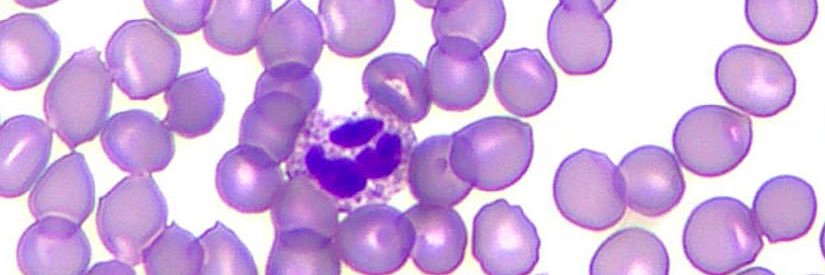
עטלף banner

עטלף
8.9K posts

Sabitlenmiş Tweet

@grok What is Israel doing to protect its civilians, including children (in terms of the number of shelters, alert systems, etc.), and what are the Palestinians in Gaza doing to protect their civilians? How do these two different approaches reflect on the number of civilian deaths on both sides?
English

@0xprimdotfun @CarlosIIdeEspna Wow, like any parrot, you're good at reproducing the text they taught you. Can you come up with something yourself?
English

@CarlosIIdeEspna It’s a multi-generational cult driven by land theft and western propaganda to enrich the military industrial complex
English

Literally the opposite of what happens.
Mr. Gbenga 🇺🇸 🇮🇱@PopoolaAyomiku2
The more Israeli history you know The more pro Israel you will be. 🇮🇱🇮🇱🇮🇱
English
עטלף retweetledi

@EylonALevy @AydogTrancer 98% of your sick society are thugs. Not just the pig Ben Khara Kbeer little British fairy.

English
עטלף retweetledi

@koshercockney These people are not ridiculous, these people are pure evil. Imagine that mindset where it is normal to act and tell the most outrageous lies just to hurt someone. Evil!
English
עטלף retweetledi

The Committee to Protect Journalists, the organization that Nicholas Kristof used as a major source for his "dog rape" story, has been caught silently removing the names of people from their list of journalists killed in Gaza.
Because those "journalists" turned out to be less interested in reporting the news and more interested in killing Jews.
Instead of acknowledging that they mistakenly put the names of terrorists on their journalist list, they silently deleted them instead.
Because acknowledging they made a mistake would be giving Israel a little bit of credit, and they'd rather do anything than that.

English
עטלף retweetledi
עטלף retweetledi

@thiagoavilabr Horrible. I hear they were raped by trained Spanish bulls afterwards. Or was it Pedro Sanchez? I'm not sure anymore, but these vampiric Spaniards need to be stopped!
English

@tiagoguilhermef Yeah right.
x.com/MorEdge_Insigh…
Mor Edge Insight@MorEdge_Insight
Miracles do indeed happen 🤭 A young German female activist from the latest Gaza flotilla was filmed by media in a neck-brace with her face looking “bruised and battered”, her expression tearful and “traumatized” after being held for a few hours in Israel. But then…. The Miracle 🤣 Just a couple of hours later, the same young German female activist was filmed perfectly fine, bouncing around, smiling and cheering… no bruises, no marks, no neck-brace, no injuries, no anything in fact. It is simply incredible the superhuman powers of recovery she showed. Even Wolverine and the X-Men would be jealous 😂
English
עטלף retweetledi

Spain has positioned itself as one of Europe’s loudest anti-Israel voices yet when flotilla members blocked the arrivals gate for their photo op, Spanish authorities handled them with a level of force they would instantly condemn if Israel did the same.
That’s the whole hypocrisy in one scene: governments holding Israel to standards they can’t meet for five minutes in their own airports.
So will the world call for boycotts of Spain? Will activists flood the streets? Will celebrities post black squares and moral lectures?
We both know the answer.
English


Ne znam što bih ti rekao. Tko u današnje vrijeme ozbiljno shvaća medije, uopće mi ga nije žao. Nek jede i 6 puta dnevno 😀 Nekad je situacija bila takva da smo se kroz medije informirali, a obrazovali smo se na drugim mjestima i drugim sredstvima. Danas mediji "obrazuju" idiotske potrošače. Moraš jesti to to i to, to i to nikako! Onda moraš pozobati te i te suplemente i dodatke. Oprati se moraš s tim i tim, da bi se potom namazao i natrackao s tim, tim i tim. E onda moraš ići kod psihologa jer si u kurcu, a svakako moraš raditi to i to. Za sve to ti je dan od 24 sata malo.... Ne, definitivno mi nije žao ljudi koji šuše sva ta sranja.

@atalef3 Post je iskonski lijek koji ne zahtjeva doslovno ništa, samo snagu volje. O tome se vrlo rijetko govori.
S druge strane, mjesečno čujem/pročitam/vidim na TV barem 20 puta da treba jesti 5 obroka dnevno.
Kužiš koliko smo bombardirani od industrije?
Uz 4 obroka:20% manji profit!
עטלף retweetledi

The world is about to get a master class in antisemitism.
Israel's minister Ben Gvir's behavior towards the flotilla activists was unacceptable. I said so myself.
World leaders all posted angry denunciations of the Israeli government and summoned Israeli ambassadors for a dressing down.
Here, the same activists are receiving much more brutal treatment at the hands of the Spanish government. What we won't see however is an international outcry against the Spanish government.
This imbalance isn't due to the vagaries of international diplomacy. People hold the Jewish state to a higher standard than they do any other state, and fundamentally it's due of bigotry and hatred.
@AnitaAnandMP
English

@BladeGunner6 Doslovno jedem 2 puta dnevno s tim da jutarnji obrok i ne bi nazvao obrokom iako to tehnički jest. Ne znam kad ljudi stignu jesti 5 puta dnevno, ili odakle im tek za takvo što. Prehrana mora biti realna, mora se uklopiti u način života.

@atalef3 A oni ne uzimaju taoce, vec ruse sve pred sobom.
Isto tako i dogma o 5 obroka je SRANJE, sto mi se dokazuje svaki Bozji dan.

Ne mijenja ti puno na stvari. Ako ne možeš spriječiti oštećenja krvnih žila, onda barem smanjiš kolesterol. Idealno je i jedno i drugo, ali jbg ne živimo u idealnom svijetu.
Treba čitati stručnu literaturu, a ne ono što novine prenose. Nije stručna literatura blaga prema šećeru... Problem je što 90% ljudi spoznaje/informacije dobiva iz medija. Mediji su katastrofa. Doma imam 2 kartonske kutije novinskih isječaka s takvim glupostima. Nekad davno sam to skupljao, sad mi žao baciti.

@atalef3 Kolesterol u zili dolazi na vec mehanicko ostecenje zile, trebalo bi istrazivati zasto nastaju ta ostecenja, a ne smanjiti masnoce u hrani.
Ne istrazuje se jer bi mozda rezultati bili nepovoljni za industriju secera.

@BladeGunner6 Ne može kolesterol činiti 20% mozga, nešto nije u redu s tim podatkom.

@atalef3 Svaka cast tvom klinickom iskustvu, ali ne vjerujem u te parametre, tj. ne vjerujem u te parametre promatrane izolirano i mehanicisticki.
20% mozga je kolesterol, mozda zato svi imaju alzheimera jer je smanjen unos masnoca, dakle gradivnih tvari mozga?

Ma gel, nije da nemam metodoloških zamjerki kad su nutricionisti u pitanju. Govorim iz neog kliničkog iskustva. Ljudi koji se drže smjernica (a takve su da se maslac ne preporuča) uspiju izregulirati određene parametre. Oni koji previše vjeruju portalima ne baš. I kad govorimo o prehrani uvijek treba imati na umu da moramo gledati ukupnost, a ne pojedine namirnice.












